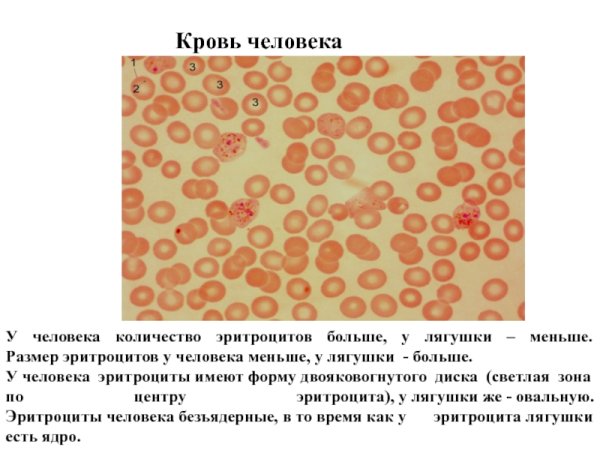
Микропрепарат крови лягушки
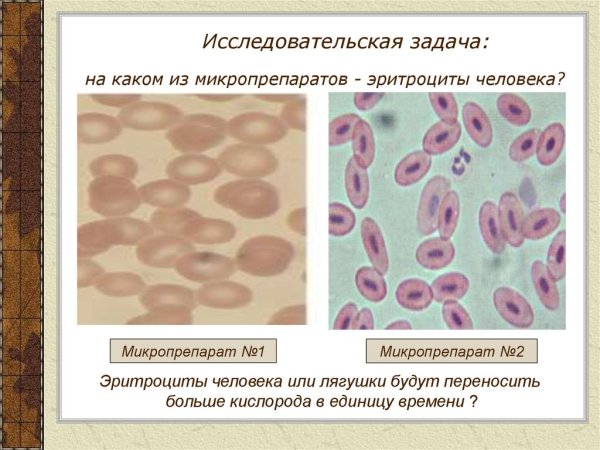
Микропрепарат крови лягушки

Кровь лягушки рисунок – это уникальное изображение, которое захватывает взгляд и привлекает внимание. Разнообразие цветов и оттенков, используемых в этом рисунке, создает эффект глубины и реалистичности. Отчетливо видны контуры и детали капель крови, расположенных на поверхности листа или другого материала, что добавляет особый шарм и интригу данному изображению. Кровь лягушки рисунок может быть использован в качестве декораций для различных проектов, таких как постеры, обложки книг, альбомы и многое другое. Этот рисунок подчеркнет вашу творческую индивидуальность и станет ярким акцентом в любом дизайне.
Клетка эритроцита лягушки под микроскопом
Микропрепарат крови лягушки
Препарат крови лягушки лейкоциты
Строение эритроцита крови лягушки
Микроскопическое строение крови
Лейкоциты в крови лягушки строение
Микропрепарат крови лягушки
Структуры клеток крови лягушки
Клетка мазок крови лягушки
Строение клетки крови лягушки под микроскопом
Микропрепарат крови лягушки
Клетки крови лягушки под микроскопом
Кровь лягушки и человека сравнение
Форма эритроцитов в крови лягушки
Кровь лягушки
Лейкоциты в крови лягушки
Эритроциты крови лягушки гистология
Клетки крови человека и лягушки под микроскопом
Лейкоциты в крови лягушки под микроскопом
Лейкоциты в крови лягушки под микроскопом
Клетки крови человека под микроскопом
Микропрепарат крови человека под микроскопом
Кровь лягушки гистология препарат
Микропрепарат крови лягушки
Микроскопическое строение крови
Микропрепарат крови лягушки строение
Мазок крови гистология препарат
Строение эритроцитов человека и лягушки
Лейкоциты в крови лягушки строение
Строение клетки крови лягушки
Строение крови человека с кровью лягушки
Строение эритроцита крови лягушки
Лабораторная работа биология кровь лягушки
Микропрепарат крови лягушки
Клетки крови лягушки рисунок
Строение эритроцита крови лягушки
Эритроциты лягушки под микроскопом
Строение эритроцитов крови человека и лягушки
Рассмотрите рисунок и заполните таблицу
Строение клетки крови эритроциты
Строение крови лягушки под микроскопом
Строение эритроцитов лягушки рисунок
Форма клетки эритроцитов человека и лягушки
Препарат крови лягушки лейкоциты
Клетки крови лягушки под микроскопом рисунок
Строение клетки эритроцита лягушки
Мазок крови лягушки гистология
Эритроциты гистология строение
Строение эритроцитов лягушки рисунок

Grizly.club
Grizly.club